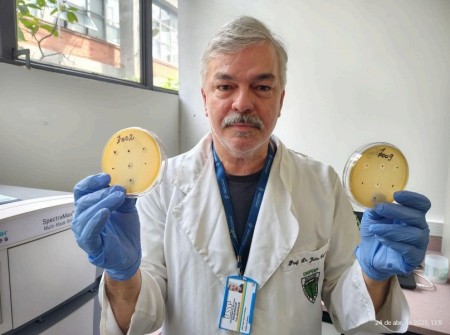

Julio Cezar Franco, a professor at UNIFESP, conducted the experiments at IQ-USP (photo: Comunicação-CEPID B3)
Bacteriophages, or phages for short, can kill bacteria and may be used to combat hospital infections and food contamination.
Bacteriophages, or phages for short, can kill bacteria and may be used to combat hospital infections and food contamination.

Julio Cezar Franco, a professor at UNIFESP, conducted the experiments at IQ-USP (photo: Comunicação-CEPID B3)
Agência FAPESP* – A collaboration between three FAPESP Research, Innovation, and Dissemination Centers (RIDCs) – the Biology of Bacteria and Bacteriophages Research Center (CEPID B3), the Antimicrobial Resistance Institute of São Paulo (ARIES Project), and the Food Research Center (FoRC) – has resulted in the discovery of 62 new types of phages. Phages are viruses that infect bacteria.
These findings pave the way for developing biological control strategies against bacteria of medical and industrial interest, such as those responsible for hospital infections or food contamination.
Julio Cezar Franco, a professor at the Federal University of São Paulo (UNIFESP) and CEPID B3 researcher-collaborator, led the project. It was conducted in partnership with the Environmental Company of the State of São Paulo (CETESB) and the São Paulo Zoo.
The year-long project was Franco’s initiative. During his sabbatical, Franco left his activities at the Diadema campus of UNIFESP and worked at the Institute of Chemistry of the University of São Paulo (IQ-USP), where CEPID B3 is based. There, he collaborated with Professor Aline Maria da Silva (1959-2024).

During the project, Franco also explored the artistic side of his research by creating physical models of bacteriophages (photo:
Comunicação-CEPID B3)
The initial phage and bacterial samples came from ARIES at UNIFESP and CETESB, the state agency responsible for controlling and monitoring pollution-generating activities in São Paulo.
“I spoke with Ana Gales, vice-coordinator of ARIES, and she put me in touch with Maria Inês Sato, manager of the Environmental Analysis Laboratories at CETESB. The agency periodically collects samples from sewage treatment plants in Greater São Paulo, where it’s possible to find various phages capable of infecting intestinal bacteria, for example. The samples provided by ARIES came from different places, such as airports and hospitals,” he says.
The researcher collaborated with the São Paulo Zoo, which provided compost samples. A new partnership was also established with USP’s RIDC FoRC, which provided samples of bacteria that are important for food safety, including the bacteria responsible for salmonellosis.
With these samples in hand, Franco began isolating the phages and testing them against the bacteria. To accomplish this, he cultivated the microorganisms of interest on nutrient-filled plates until they covered the entire surface. He then deposited a small amount of each sample containing phages at several spaced points. If the virus in the sample could infect and kill the bacteria, transparent spaces would appear on the “carpet of bacteria,” called lysis plates. “This is where the phage killed the bacteria,” he explains. He repeated the process hundreds of times and yielded unprecedented results. “In the end, I managed to isolate 62 new phages,” Franco says.
The findings represent an important academic breakthrough and have the potential to boost new strategies in areas such as health, industry, and food. “This work helps to find alternatives to combat antibiotic-resistant bacteria, a serious problem in hospitals,” says the researcher. He also points to the possibility of using some of these phages to control contaminating bacteria in food and prevent disease outbreaks.
Franco stresses the importance of creating collections and banks of isolated phages to make these solutions viable for use in phage therapy, which is part of the project’s outlook for the coming years.
“Now is the time to isolate the DNA, sequence the genomes of the bacteria and the phages, and carry out more in-depth studies of these interactions, find out how the virus infects the bacteria, and look for ways to increase efficiency,” he says.
According to Franco, the goal is to stimulate further partnerships between RIDCs and interactions between students from different institutions. “Everything you plant now has the chance to develop, and you can reap the rewards later. These are public universities that are focusing on science to solve public health problems. The objectives are common, and the demands are society’s,” says the researcher, who will continue to work simultaneously as a CEPID B3 collaborator and a UNIFESP lecturer.
* With information from Bianca Bosso from CEPID B3.
Republish
The Agency FAPESP licenses news via Creative Commons (CC-BY-NC-ND) so that they can be republished free of charge and in a simple way by other digital or printed vehicles. Agência FAPESP must be credited as the source of the content being republished and the name of the reporter (if any) must be attributed. Using the HMTL button below allows compliance with these rules, detailed in Digital Republishing Policy FAPESP.





